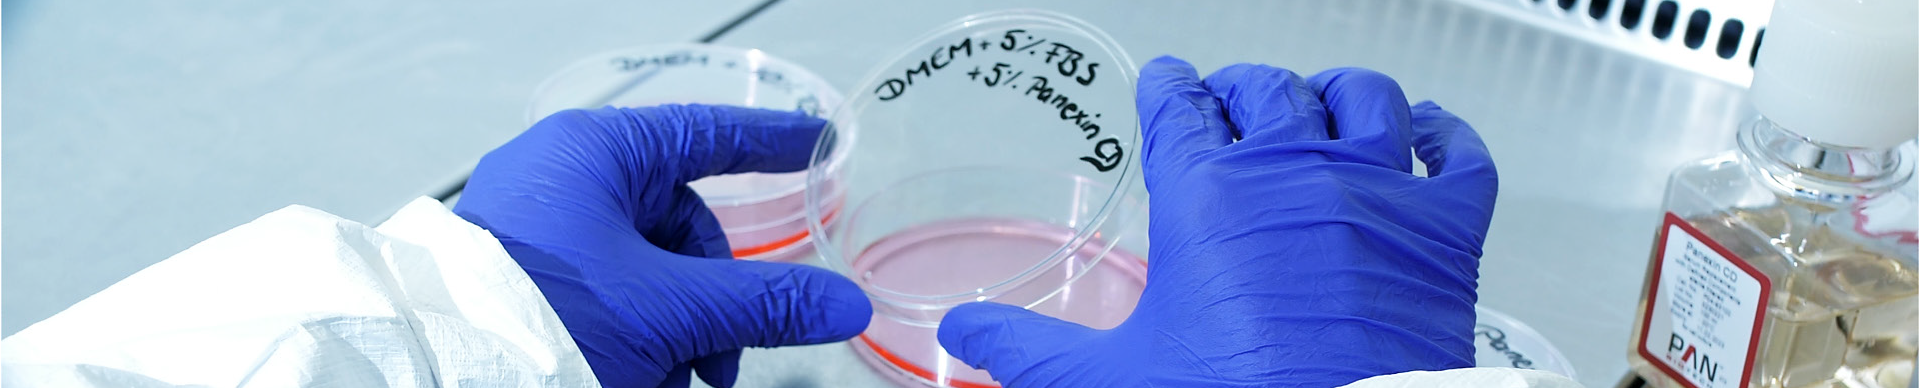

/ REPLACE
Serumfreie Alternativen
Panexin-Produkte sind definierte Serumersatzprodukte, die von PAN-Biotech entwickelt wurden. Sie können zur Kultivierung adhärenter und nicht-adhärenter Zellen sowohl serumfrei als auch serumreduziert eingesetzt werden. Für wichtige Vollzelllinien haben wir außerdem Panexin NTA (adhärente Zellen) und NTS (Suspensionszellen) entwickelt.

Erleben Sie zuverlässige Ergebnisse und begeistern Sie mit Qualität!
Mit unseren serumfreien Produkten kann der Serumverbrauch deutlich reduziert oder vollständig ersetzt werden.
- Hohe Chargenkonsistenz: reproduzierbare Ergebnisse und minimale Variabilität
- Gebrauchsfertig: kein zeitaufwändiges Serum-Screening erforderlich
- Unterstützt verantwortungsvolle Wissenschaft: frei von ethischen Bedenken im Zusammenhang mit tierischem Serum
- Reduziertes Kontaminationsrisiko
- Kostengünstige Alternative
- Konformität mit gesetzlichen
- Vorschriften: erfüllt pharmazeutische und etablierte Industriestandards
- GMP-konform
Anwendungen
Als Serumersatz oder Mediumzusatz zur Steigerung der Produktivität in industriellen Zellkulturen (CHO, MDCK, Vero, Hybridoma usw.)
- Um Exosomen oder stimulierende Effekte von Wachstumsfaktoren im Serum zu vermeiden
- Um das Überwachsen der Kultur durch Fibroblasten in Kokulturen oder in hochdifferenzierten epithelialen Primärkulturen zu verhindern
- Um die Reproduzierbarkeit und Sensitivität in zellbasierten In-vitro-Tests zu gewährleisten.
- Um die Serummenge generell aufgrund ethischer Bedenken, Chargenvariabilität oder hoher Kosten zu reduzieren.
Übersicht verschiedener serumfreier Produkte
